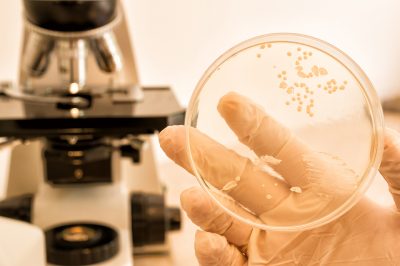

Οκτώβριος 2017
Οκτώβριος 2017
Οκτώβριος 2017
Οκτώβριος 2017
Οκτώβριος 2017
Οκτώβριος 2017
Οκτώβριος 2017
Οκτώβριος 2017
Οκτώβριος 2017
Οκτώβριος 2017